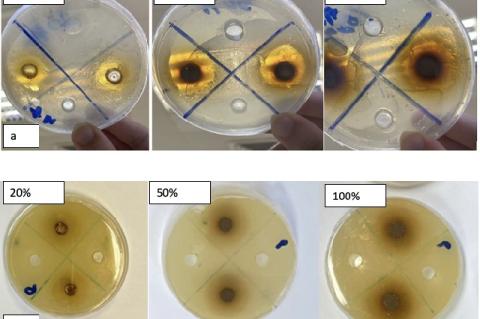
The inhibition zone (cm) of aqueous extracts of clove (0%, 20%, 50%, 100%) on (a) Staphylococcus aureus and (b) Cryptococcus neoformans.

sys1
Latest posts from sys1
Latest
In vitro Assessment of Antibacterial Potential of Chrozophora rottleri Fruit Different Extracts against Common Pathogens
1 year 5 days ago [comment_count]
Read more
Molecular Structure, Metabolic Pathways and Clinical Relevance of Arginase: A Review
1 year 2 months ago [comment_count]
Read more
Clove (Syzygium aromaticum) Extract has Antibacterial and Antifungal Effects against Human Scalp Microbes
1 year 2 months ago [comment_count]
Read more
Heat Stress-Induced Changes in Growth and Essential Oil Profile of German Chamomile (Matricaria chamomilla)
1 year 2 months ago [comment_count]
Read more